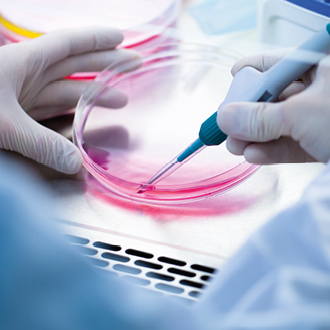

X

24.03.2025
Luther advises hVIVO plc. on the acquisition of two German research units from CRS Clinical Research Services

26.02.2025
New partner from March 2025: Luther gains experienced expert in real estate law, Lars Bollensen
04.02.2025
Biotechnology company Medix Biochemica succeeds in a strategic acquisition with Luther's support





